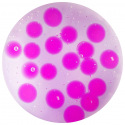

Mac Toys Nickelodeon Hydro sliz smradlavý
Kód: i48_M1123294Skladem
Termín a způsob doručení
Hydro sliz smradlavý se třpytkami a korálky. Sliz je tekutý, krásně se hýbe.
Vyberte si zvýhodněné balení
Množstevní slevy
Dotaz
Hlídat
Sdílet
Parametry
Kód:
i48_M1123294
EAN:
5056219002460
Záruka:
24 Měsíců
Vhodné pro:
Pro holčičky, Pro kluky
Věk dítěte:
3-5 let
šířka:
20
hloubka:
3.5
Naposledy navštívené produkty